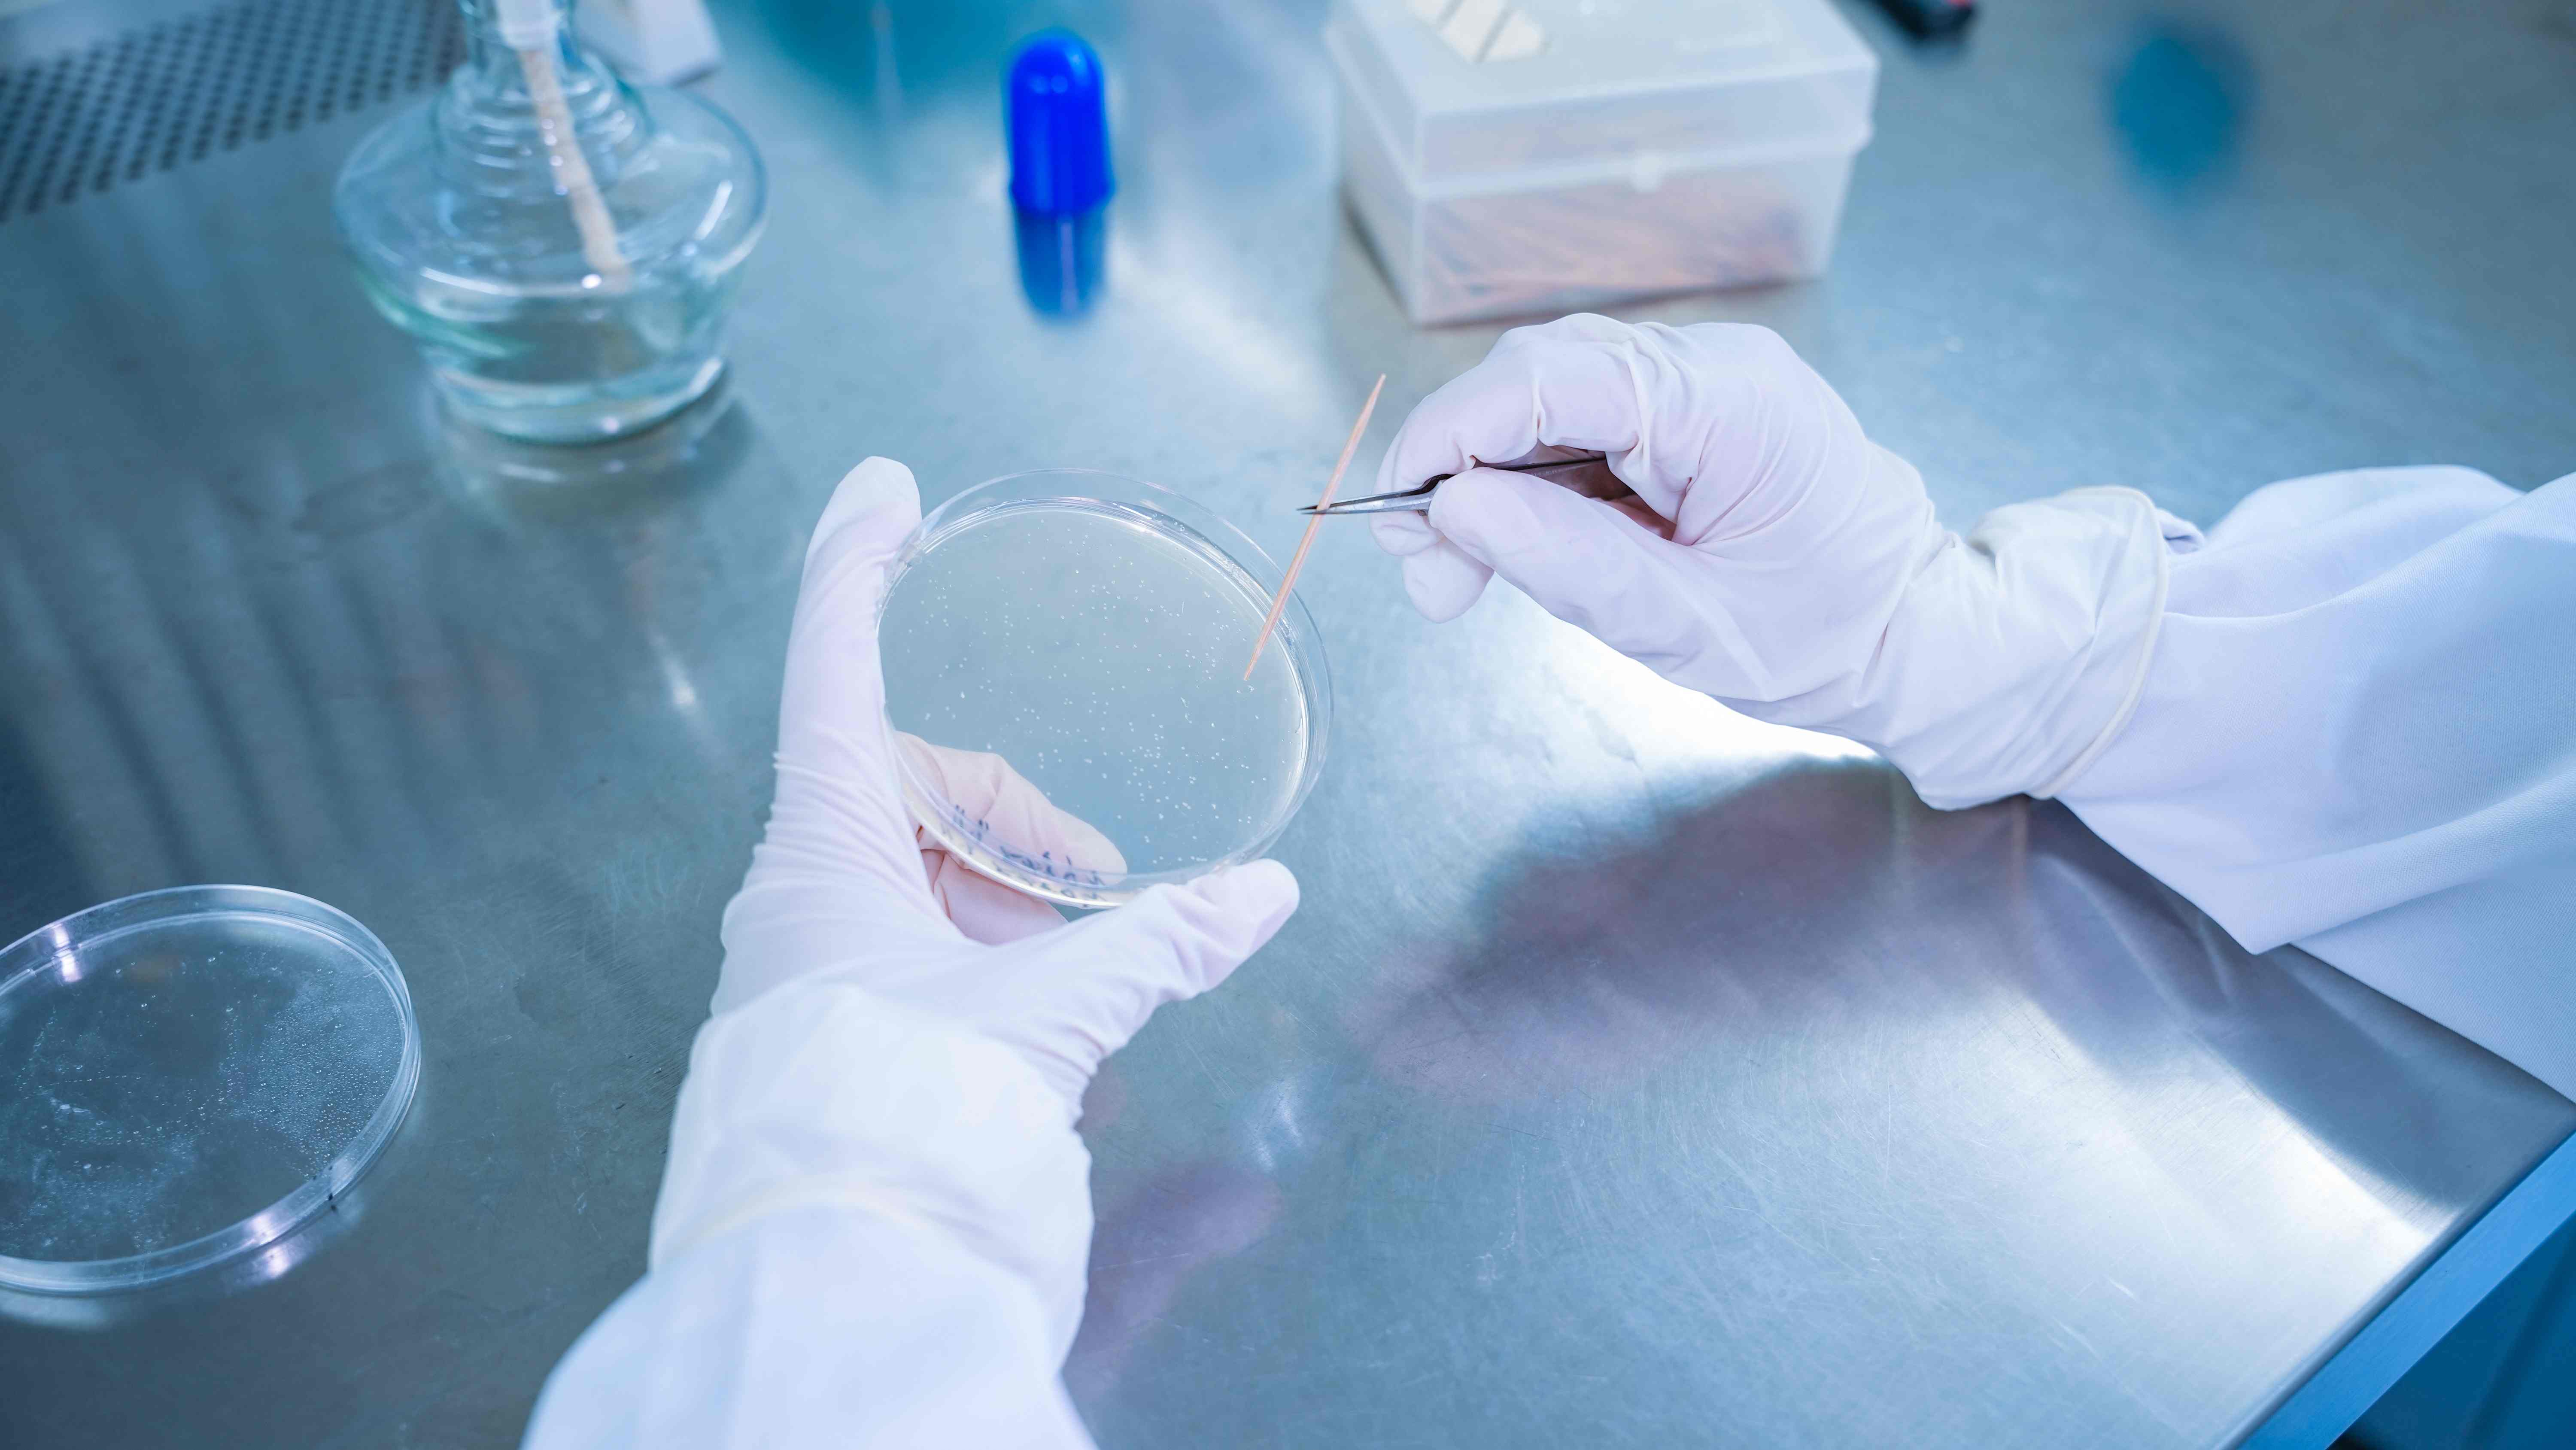
分子克隆与检测平台

王度打造了一套贯穿分子到产业的全链条技术平台,涵盖分析检测、分子克隆、细胞编辑、胚胎工程、养殖验证及兽药研发。该平台为公司自主研发与创新探索提供了系统支撑,并推动科研成果向产业转化。公司已形成以猪、牛、鼠、鱼为核心的胚胎技术平台,覆盖体细胞克隆、显微注射、体外受精、胚胎冻存、活体采卵与胚胎移植等前沿实验方法,为种质创新、遗传育种与基础科研提供系统支撑。
分子克隆与检测平台
依托完善的分子生物学实验体系和先进仪器设备,王度建立了覆盖DNA提取、PCR扩增、RT-qPCR定量分析、体外酶切验证与TA克隆的完整检测流程,用于基因编辑事件的精准确认。同时,公司具备成熟的大片段基因合成与高效载体构建能力,能够支持多样化的分子克隆研究。平台还建设了系统的蛋白检测体系,涵盖蛋白表达与纯化、ELISA、Western Blot、原位杂交与双荧光素酶报告基因检测,为基因功能解析与蛋白表达研究提供有力支撑。此外,王度还开展了基于PCR、RT-qPCR及ELISA的病毒和细菌检测方法,为动物疫病研究与防控提供可靠的数据基础。

细胞编辑平台
公司建立了完善的基因编辑平台,具备从sgRNA设计到阳性细胞筛选的完整能力。该平台已应用于猪、牛、鼠、鱼等多物种,能够实现多类型的工程化细胞系构建,包括单/多基因敲除、敲高、点突变、定点整合及过表达细胞株开发,为产业化应用与前沿研究提供有力支撑。





哺乳动物胚胎工程平台
王度专注于猪、牛、鼠和鱼的胚胎工程研究,构建了从基础到前沿的多环节技术体系。在猪方面,平台具备体细胞克隆、显微注射、体外受精(IVF)、胞浆内单精子注射(ICSI)、器官嵌合、活体采卵、胚胎移植等能力,用于种猪改良与相关研究;在牛方面,以体细胞克隆与体外受精为核心,并配套胚胎冷冻与解冻及显微注射技术,活体采卵与胚胎移植,支撑肉牛和奶牛的优良育种;在鼠方面,开展四倍体补偿实验,并结合显微注射、体外受精及胚胎冻存技术,用于模式动物构建与生命科学研究。






鱼胚胎工程平台
王度专注于猪、牛、鼠和鱼的胚胎工程研究,构建了从基础到前沿的多环节技术体系。在鱼方面,形成了涵盖鱼卵显微注射、三倍体制种、伪雄鱼诱导、雌核发育等的完整体系,并结合精子冻存、体外受精与细胞移植,用于基因编辑、转基因育种和功能基因研究。





养殖平台
王度自主建立了覆盖猪、牛、鼠、鱼四大类物种的标准化、规模化养殖与表型评估体系,为基因编辑动物的性状研究与成果验证提供可靠支撑。牛方面,平台饲养西门塔尔、海福特、荷斯坦等主要品种;猪涵盖美系大白长白、丹系长白大白及其杂交、回交二元等类型;鼠以ICR、C57、DBA、BALB和NUDE等为核心;鱼则包括斑马鱼、虹鳟、大西洋鲑等。
猪牛养殖平台






鼠房养殖平台




斑马鱼养殖平台



虹鳟养殖平台




